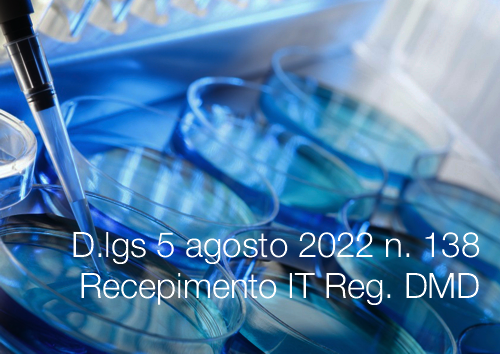

DLgs. di adeguamento IT ai Regolamenti MD e IVDMD 2022
| ID 17586 | | Visite: 3637 | News Marcatura CE | Permalink: https://www.certifico.com/id/17586 |
Regolamenti MD e IVDMD / In vigore dal 28 Settt. 2022 i DLgs.di adeguamento IT
ID 17588 | 28.09.2022 / Download Scheda
Pubblicati in GU n. 214 del 13.09.2022 i Decreti Legislativi di adeguamento della normativa nazionale al regolamento (UE) 2017/745 (MD) ed al regolamento (UE) 2017/746 (IVDMD) che entrano in vigore il 28 Settembre 2022 - Transitori in dettaglio.
1. Decreto Legislativo 5 agosto 2022 n. 137 - Disposizioni per l'adeguamento della normativa nazionale alle disposizioni del regolamento (UE) 2017/745 (GU n.214 del 13.09.2022)
2. Decreto Legislativo 5 agosto 2022 n. 138 - Disposizioni per l'adeguamento della normativa nazionale alle disposizioni del regolamento (UE) 2017/746 (GU n.214 del 13.09.2022)
Fig. 1 - Schema DLgs. di adeguamento IT ai Regolamenti MD e IVDMD
_______
Dettagli Testi / Transitori nella Scheda allegata

Decreto Legislativo 5 agosto 2022 n. 137
Disposizioni per l’adeguamento della normativa nazionale alle disposizioni del regolamento (UE) 2017/745, relativo ai dispositivi medici, che modifica la direttiva 2001/83/CE, il regolamento (CE) n. 178/2002 e il regolamento (CE) n. 1223/2009 e che abroga le direttive 90/385/CEE e 93/42/CEE del Consiglio, nonché per l’adeguamento alle disposizioni del regolamento (UE) 2020/561, che modifica il regolamento (UE) 2017/745 relativo ai dispositivi medici, per quanto riguarda le date di applicazione di alcune delle sue disposizioni ai sensi dell’articolo 15 della legge 22 aprile 2021, n. 53 (GU n.214 del 13.09.2022).
...
Decreto Legislativo 5 agosto 2022 n. 138
Disposizioni per l’adeguamento della normativa nazionale alle disposizioni del regolamento (UE) 2017/746, relativo ai dispositivi medico-diagnostici in vitro e che abroga la direttiva 98/79/CE e la decisione 2010/227/UE della Commissione, nonché per l’adeguamento alle disposizioni del regolamento (UE) 2022/112 che modifica il regolamento (UE) 2017/746 per quanto riguarda le disposizioni transitorie per determinati dispositivi medico-diagnostici in vitro e l’applicazione differita delle condizioni concernenti i dispositivi fabbricati internamente ai sensi dell’articolo 15 della legge 22 aprile 2021, n. 53 (GU n.214 del 13.09.2022).
...
Collegati
Decreto Legislativo 5 agosto 2022 n. 138
Regolamento (UE) 2017/745
Regolamento (UE) 2017/746
Tags: Marcatura CE Regolamento Dispositivi Medici Regolamento DMD Vitro